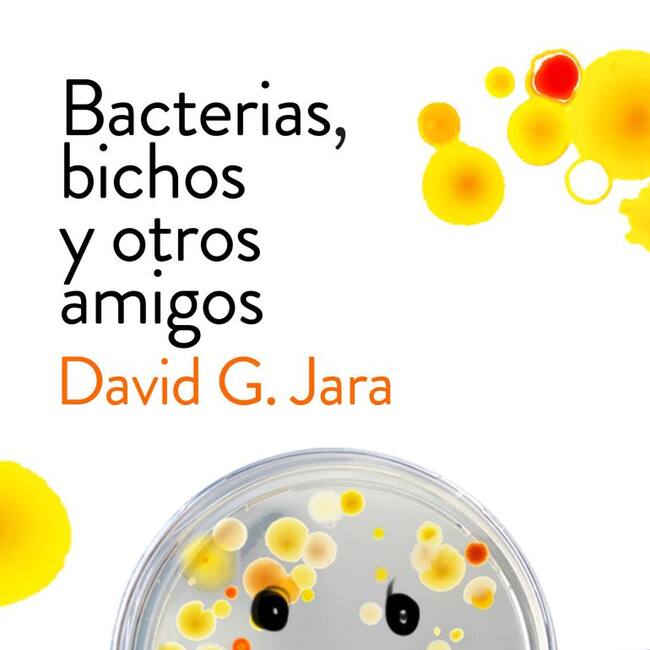

Literatura en corto: Bacterías, bichos y otros amigos
El científico y profesor abulense David González Jara habla de su última obra
Portada del libro / Editorial Ariel

Ávila
Un libro de divulgación científica que trata de acabar con los falsos mitos que reodean a estos microorganismos necesarios para la vida. David González Jara conversa con Pablo Garcinuño y Luis Sánchez.
El código iframe se ha copiado en el portapapeles
Literatura en corto 23 septiembre

Luis Sánchez
Licenciado en Ciencias de la Información por la Universidad Complutense de Madrid. Redactor en Ser Ávila...




